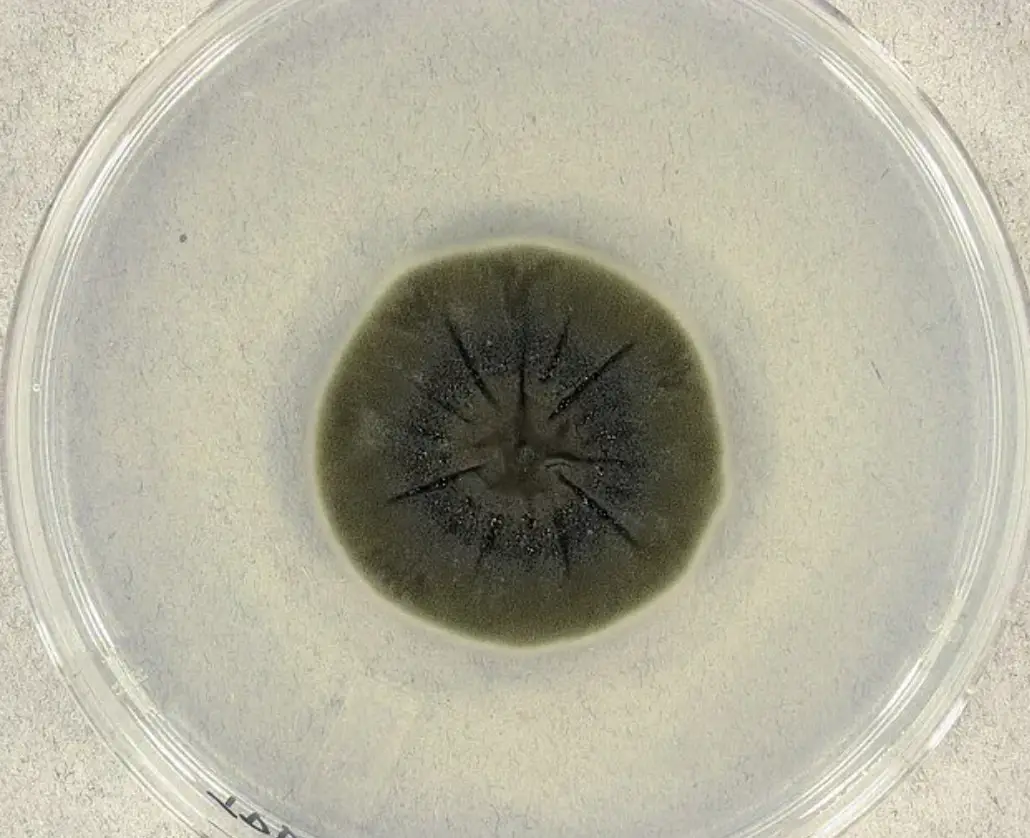
The black fungus has been found to absorb radiation (PA)

While fungus growing inside a building is typically seen as a bad thing, this unique organism is actually proving useful.
Fungus grows anywhere and everywhere, and if you saw some starting to develop on the wall of your apartment, I can't imagine you'd be very pleased.
The same could be said when you discover mold on the loaf of bread you forgot about in the cupboard.
While fungi might get a bad rep, this particular type is said to be helping absorb radiation in Chernobyl.
Advert
A black fungus called Cladosporium sphaerospermum has been found growing on the walls of Chernobyl's infamous No. 4 reactor - where one of the most dangerous objects on Earth is found.
Upon the reactor exploding in 1986, the entirety Pripyat was forced to evacuate and, to this day, people are still forbidden from living in the exclusion zone.
In the immediate aftermath of the explosion almost 40 years ago, radiation levels hit a whopping 20,000 roentgens per hour.
To put that into perspective, just 50 -100 roentgens is enough to cause radiation sickness in a person, while being exposed to around 500 roentgens over five hours is enough to kill you.

Over the years, radiation levels have significantly dropped, so much so that people are now able to visit the historic site as tour guides have created safe routes to take around the plant.
The reason the levels will have dropped will largely be down to the radiative material dispersing into the atmosphere and gradually decaying over the years, but Cladosporium sphaerospermum and other fungi known as ‘radiotrophic fungi’ may have also played a part as well, Metro Online reports.
The fungi in question was first discovered back in the 1990s, and it uses the radiation for its metabolic process meaning the more radiation it absorbs, the more it grows.
It's also hoped that such fungi could help protect astronauts on deep space missions from cosmic radiation.
Researchers have previously sent radioactive fungi samples taken from Chernobyl to the International Space Station.
After monitoring the samples for 30 days, it was found to reduce radiation by two percent, in comparison to a non-radioactive sample.
Raving about Cladosporium sphaerospermum and its many perks, Nils J.H. Averesch, who co-authored a study on the famous fungus, told SyFy back in 2020: "C. sphaerospermum out-competes other organisms in this non-natural habitat (foremost in the contamination radius around the plant), due to its apparent radio-resistance.
"There is also an indication that the organism can utilize certain forms of highly energetic ionizing and non-ionizing radiation as a metabolic support function, effectively allowing it to grow faster than normal, which probably have led to the fungus populating the radioactive sites."